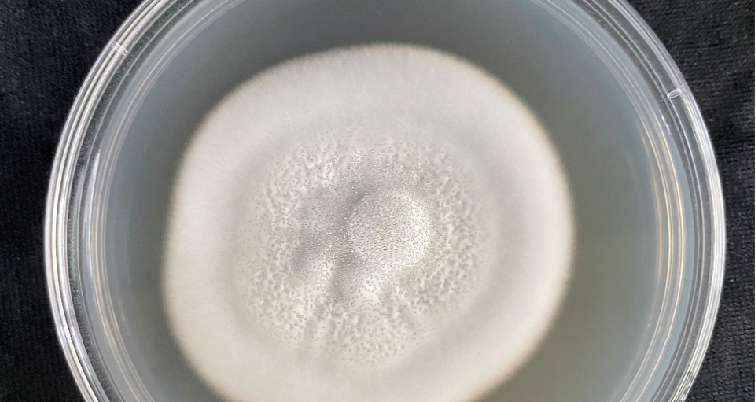
图片5.png

蛹虫草深层发酵因子ShroomGlow CM,荣获国家发明专利证书!这标志着迪美在抗衰护肤领域取得了又一重大突破!


研发背景

广东省科学院微生物研究所真菌标本馆,是华南地区最大且极具特色的菌物博物馆。真菌标本馆立足华南、面向全国乃至全球,以热带、亚热带真菌资源为特色。
馆藏真菌标本超过10万号,涵盖2000多种真菌。馆内展出百余种食、药用菌,20多种灵芝(包括世界最早人工栽培的标本)等400余份真菌实物标本。
蛹虫草介绍
提及虫草,您或许第一时间想到冬虫夏草。但您知道吗?蛹虫草中的虫草多糖、虫草素含量均远高于冬虫夏草!
蛹虫草又称北冬虫夏草、虫草花,与冬虫夏草同属虫草科成员。蛹虫草活性成分含量丰富,主要成分有蛋白质、氨基酸、多种维生素,还含有微量元素,虫草酸、虫草素、虫草多糖和SOD酶等生物活性物质。

菌丝体液态深层发酵
市场上的蛹虫草发酵产品主要采用子实体发酵和菌丝体固态发酵技术。然而,迪美的蛹虫草深层发酵因子采用了专利发酵技术——菌丝体液态深层发酵,这不仅提升了产品的气味,而且显著提高了虫草多糖的含量。
通过低温长时间发酵,可以有效地富集代谢产物。在较低的环境温度下,菌丝体缓慢生长,发酵过程持续多天,从而得到富含代谢产物的发酵液。同时,采用酶法温和破壁技术,可以有效地保护易受热破坏的活性成分。
深层抗衰 焕活肌肤
蛹虫草深层发酵因子,拥有深层抗衰、焕活肌肤的功效,能深入肌肤底层,靶向强化DEJ层,改善肌肤老化。同时,蛹虫草深层发酵因子能激活细胞自噬,让肌肤焕发青春光彩。



蛹虫草深层发酵因子ShroomGlow CM荣获国家发明专利,通过菌丝体液态深层发酵技术,更高效地提取了蛹虫草中的活性成分,强化了其抗衰功效,为抗衰护肤领域注入了新的活力。
广东迪美始终秉持源于天然、致善致美的核心理念,将不断研发创新,为您带来更多绿色天然、安全有效的护肤原料。
若想进一步了解蛹虫草深层发酵因子,
请联系迪美业务人员为您解答!

